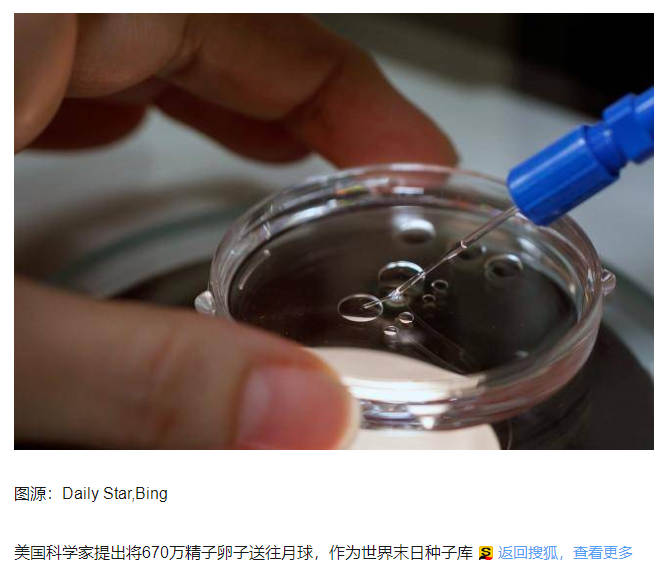

美国建世界末日人种库

实际上,建立“末日种子库”的想法并不是第一次出现,位于挪威斯瓦尔巴群岛的“种子银行
”和英国自然史博物馆与伦敦动物园的“冷冻方舟”已经开创了先河。到目前为止,这两个存
储点完整保存了足够多的植物种子和动物基因。不过它们有着一个缺点,那就是都建立在
地球之上,一旦地球发生毁灭性的灾难,无论它们的选址多么偏远,墙体建得多么坚不可
摧,也都难逃湮灭的命运。

针对这一情况,亚利桑那大学的杰坎·桑加教授提出了在月球上建立基因库的想法,将“方舟
”分成两部分,分别建立在月球地表上下,并把基因样本放置在由火山喷发形成的、直径可
达500~900米的熔岩管内,储存在-180°~-190°的环境中。而地表通过电梯与熔岩管相连
由太阳能电池提供动力,人类则可以通过安置在月球表面的通讯阵列让“方舟”实现自主维护。

一切设想都很美好,但若要真正实现,恐怕困难重重。成本问题是无法回避的,要保证将
670万种生物样本完全送上月球,需要发射数百次火箭才能完成,而发射一次至少要花费
数亿美元。粗略估计一下,光是发射成本就能达数千亿美元,这对一个国家的财政支出来
说绝对是个不小的压力。倘若再加上在月球建立基础设施和低温保存的费用,那需要花
费的金额必将更高。

同时我们知道,人类目前还无法在月球上常态化活动,需要通过机器人辅助才能完成作业,
如何保证机器人能在零下180度的环境下持续开展工作,也是一个无比困难的技术难题。

也许在未来的世界里,“月球方舟”将不再是天方夜谭,但与其担心未来会怎样,不如把
握好现在,从注重防控疾病、关注气候变化、减少地区纷争和提高科学技术水平做起,
岂不是更好?这些或许才是真正脚踏实地的路子。

霍金:人类必须在2032年之前逃离地球,否则就将随地球一同消亡

全球思想家委员会发布:
霍金:人类必须在2032年之前逃离地球,
准备移民月球!美国欲搞“末日方舟”,把670万个物种送出地球——都是痴人说梦。
人类的世界大战死亡几亿人,莫非还要引发,侵略其它星球,会引起宇宙人类战争?
人生在宇宙中的坐标
人生在宇宙中的坐标是地球,人不可离开地球而生存。
人若想进入别的星球生活,就是侵略者,会引起宇宙人类战争。
人的灵魂离体后也只能进入月球,而不能进入别的星球。
人的灵魂能进入地心,消失自己的身影。人的灵魂也可以在空间游荡,
合在生物体中生存。人的灵魂能被佛神的灵汇聚与组织,构成灵魂能量团。


美国科学家提出将670万精子卵子送往月球,作为世界末日种子库